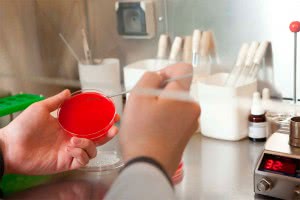
Сдайте анализ на грибок

Молочница на сегодняшний день является очень распространенным заболеванием, которое может поражать человека в любом возрасте. Грибок кандида, живущий в организме человека начинает активно размножаться под воздействием благоприятных для него факторов, в результате чего возникает заболевание. Кандидоз с успехом лечится современными препаратами, в частности, свечами Виферон.
Если не затягивать обращение к специалисту, который в результате исследований поставит правильный диагноз, то можно быстро избавиться от молочницы. Хроническая и скрытая форма заболевания приводит иногда к тяжелым последствиям, и лечить болезнь в этой форме значительно сложнее. Нельзя самостоятельно начинать прием различных препаратов от молочницы. Без постановки точного диагноза трудно понять, действительно ли симптомы, которые человек наблюдает у себя, являются проявлением кандидоза. В связи с этим лечение может быть бесполезным и даже вредным. Поэтому, прежде чем употреблять лекарства, нужно сдать анализы на выявление грибкового заболевания.
Лечение кандидоза проводится различными противогрибковыми средствами, к которым относятся таблетки, свечи, растворы и различные процедуры, которые снимают воспалительные процессы.
Симптомы, сопровождающие молочницу
-
появление неприятных зудящих ощущений в области половых органов;
- воспалительные процессы, сопровождающиеся частым и болезненным мочеиспусканием, иногда болями в животе;
- воспаление, покраснение, отечность половых органов;
- увеличение количества выделений, приобретающих форму хлопьев, а иногда окрашенных в желтый, белый и коричневый цвет;
- неприятный, сильный запах выделяемого секрета;
- налет белого или сероватого цвета на половых органах или слизистых ротовой полости.
Если обнаружены один или несколько схожих симптомов, то необходимо сразу обратиться за консультацией и сдать анализы. Только после этого может быть назначено качественное лечение молочницы, длительность которого определяет врач.
Одним из средств, используемых в комплексной терапии лечения молочницы, является Виферон.
Виферон и его свойства
-
воздействует непосредственно на зараженную область;
- начинает моментальное уничтожение грибковой инфекции, замедляя и блокируя размножение грибка;
- влияет на иммунную систему, помогая восстановить баланс микрофлоры в организме;
- практически не имеет противопоказаний, может использоваться в любом возрасте, как иммуномодулирующее средство;
- имеет широкий спектр действия и влияет на возможное развитие многих заболеваний, связанных с размножением вирусов, бактерий и грибков у детей и взрослых.
При диагностировании молочницы у женщин, рекомендуется использовать свечи Виферон, как современное средство, способное справиться с заболеванием на любом этапе его развития. Отличается Виферон от других используемых средств тем, что в его составе есть масло какао, комплекс витаминов С и Е, а также интерферон, который непосредственно воздействует на болезнетворные микроорганизмы, бактерии и грибки, не давая им возможности размножаться.
Свечи Виферон используют в комплексной терапии, в сочетании с применением других средств при кандидозе. На сегодняшний день можно говорить о том, что аналогов данного препарата нет, используя его в правильной дозировке, при подтвержденном диагнозе, можно вылечить не только молочницу, но и сопутствующие заболевания, которые часто являются причиной кандидоза.
Почему возникает молочница
- Причиной развития кандидоза могут стать хронические заболевания пищеварительной системы, которые позволяют активно размножаться грибкам и бактериям в организме. В частности, это могут быть серьезные заболевания печения, желудка, пищевода, где наиболее часто встречаются очаги поражения грибком.
- Длительный курс приема антибиотиков, уничтожает полезные микроорганизмы, способные бороться с дрожжевой инфекцией. Поэтому при длительном лечении нужно одновременно восстанавливать баланс микрофлоры, иначе после лечения одного заболевания можно столкнуться с другим, таким как молочница.
- Не соблюдение гигиенических правил, ношение синтетического узкого белья, использование концентрированных средств для мытья в ванне или душе, могут создавать благоприятные условия для активности грибка на коже.
- Многие болезни, связанные с нарушением гормонального фона также являются предвестниками молочницы. Особенно следует следить за своим здоровьем женщинам в период менопаузы и беременности, когда организм перестраивается.
-
Длительное употребление алкоголя, курение, неправильное питание с большим количеством углеводов, сахара, острых приправ, концентрированных продуктов, способствует развитию ряда хронических заболеваний пищеварительного тракта и как следствие возникновение кандидоза, который может начаться в пищеварительной системе, а в дальнейшем распространиться по всему организму.
Комплексное лечение с помощью препарата Виферон благоприятно сказывается на состоянии всего организма. Иммунная система начинает восстанавливаться и защищать организм от агрессивного проявления грибка. Это происходит под воздействием составляющих, которые входят в препараты Виферон, с помощью которых восстанавливаются не только защитные силы организма, но и происходит восстановление микрофлоры всего организма.
Использовать Виферон можно в качестве свечей, крема или геля от молочницы. Дозировка устанавливается в зависимости от степени заболевания и может отличаться при острой и хронической форме болезни. Длительность использования также определяется формой заболевания.
Свечи благоприятно сказываются на восстановлении слизистой, снятия внешних симптомов раздражения, не вызывают привыкания и побочных эффектов.
Для женщин свечи рекомендуются как основная терапия при кандидозе, особенно в остром периоде болезни.
Свечи удобны в применении, их составляющие не впитываются в кровь, благоприятно сказывается на использовании их в период беременности, исключая первый триместр.
По данным исследований установлено, что при правильном применении препаратов Виферон, возможно не использовать лечение с помощью других противогрибковых средств.
Очень часто причина возникновения кандидоза заключается в подавленном иммунитете поэтому, прежде всего, необходимо восстанавливать эти свойства организма. Виферон с успехом воздействует на иммунную систему, поэтому молочница, особенно на начальном этапе может быть вылечена с использованием только этого препарата, при соблюдении всех рекомендаций, особенно касающихся сопутствующих заболеваний.
Для того, чтобы лечение было эффективным, необходимо отказаться от:
- алкогольных напитков;
- сахара;
- дрожжевого хлеба;
- пищи с большим содержанием углеводов;
- применения антибиотиков в период лечения молочницы;
- использования контрацепции с содержанием большого количества гормонов.
Причиной возникновения молочницы может стать и длительные стрессовые ситуации, которые ослабляют организм.
Также кандидоз может начаться при перемене климата, резком перепаде температур, повышенной влажности.
Чтобы определить наличие заболевание, необходимо пройти полное обследование организма, собрать необходимые анализы и на основе всех составляющих констатировать наличие или отсутствие молочницы. Когда диагноз поставлен, то можно начать терапию с использованием Виферона и других средств, назначенных специалистом.